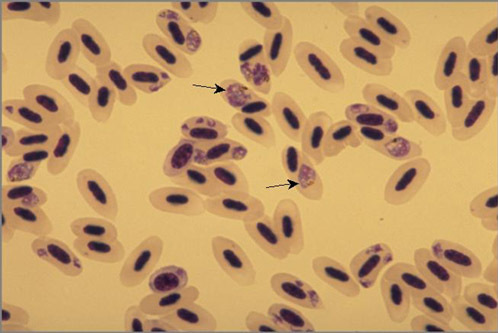

Candidiasis
Dx?
Tx?

What is the only way Aspergillus can infect?
What is the disease caused by the nodules formed in the lung called?

Mycobacterium Avium
Signs of mycobacterium infection may include:
What disease of pheasants is caused by an adenovirus that is closely related to hemorrhagic enteritis virus of turkeys?
What infectious agent is usually the cause of this classic triad of lesions?
Which species of bird does iodine deficiency most commonly occur?

Pacheco’s Disease
What is it caused by?

Herpesvirus
“Bluecomb”
(Transmissible Enteritis)
Avian Malaria
Organophosphate Poisoning

Chlamydiosis
Histomonas meleagridis
(chickens v. turkeys)


You are working as a relief veterinarian at an exotic animal practice, and a toucan is brought in for evaluation due to a history of poor feathering and an overgrown beak.
Blood work shows elevated liver enzymes and bile acids. What disease common for this species must you rule out?

Sternostoma tracheacolum

Haemoproteus

The fused lumbosacral region in birds is known as the ___________

Synsacrum

3 strains/groups of Newcastle Disease

Newcastle disease is caused by an RNA virus (paramyxovirus-1).
The disease is categorized into 3 groups:
1) Velogenic straina: highly virulent and easily transmitted
2) Mesogenic straina: moderately virulent
3) Lentogenic straina: low virulence
Clinical signs include diarrhea, swelling of the head and neck, gasping, coughing, sneezing, drooping wings, dragging legs, circling, torticollis, paralysis, and clonic spasms.
Diagnosis is based on rapidly spreading respiratory and neurologic disease, in addition to isolation of the organism.
Prevention is via vaccination.
Newcastle disease has the potential of causing a transitory conjunctivitis in humans with very high levels of exposure to the virus.
A well-known bird breeder calls to let you know she is bringing in a parrot on emergency with a “tear in the rhamphotheca and a lacerated choana”.
What anatomic structures should you be prepared to examine?

When placing an intraosseous catheter in a bird, which bones would be the most appropriate to use?
ULNA or TIBIOTARSUS

Treatment for Chronic Egg Laying
Leuprolide acetate (Lupron)
A primarily seed diet in birds can lead to?
proventricular dilatation syndrome
Allopurinol